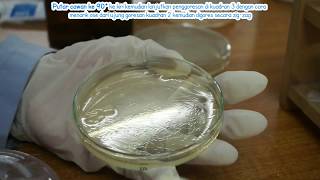

- PROSEDUR PENGAMBILAN USAP PERALATAN.flv

KANTOR KESEHATAN PELABUHAN KELAS I TANJUNG PRIOK PELATIHAN PENGAMBILAN SPESIMEN KESEHATAN LINGKUNGAN BAGI PETUGAS ... Watch Now
Watch Now
- Evironmental Swabbing How-To - ABC Research Laboratories

http://abcr.com/ - The dos and don\'ts of how to collect samples for environmental swab testing. Be sure annotations are on so you can skip to the appropriate ... Watch Now
Watch Now
- UJI ALT / TPC Part 2 Cara menghitung jumlah bakteri pada media PCA sesuai SNI ALT 2015

bagaimana ciri ciri bakteri yang tumbuh di media pca? bagaimana cara menghitungnya? Watch Now
Watch Now
- Pengenceran Bertingkat Mikrobiologi

Tujuan dari pengenceran bertingkat yaitu memperkecil atau mengurangi jumlah mikroba yang tersuspensi dalam cairan. Penentuan besarnya atau banyaknya ... Watch Now
Watch Now
- Prosedur Pengambilan Usap Alat Makan

Education. Watch Now
Watch Now
- [Video Tutorial] Teknik Goresan Kuadran
Teknik goresan kuadran merupakan teknik yang sangat esensial dalam pengerjaan di laboratorium mikrobiologi. Teknik ini sering digunakan dalam proses ... Watch Now
Watch Now
- praktikum parasitologi 1 metode anal swab

UNIMUS DIV Teknologi Laboratorium Medik. Watch Now
Watch Now
- Cara Menghitung Bakteri E. Coli Dan Coliform Pada Media Agar #sanitariankit_episode2

Tujuan vidio ini di buat untuk mengingatkan kembali teman - teman sanitarian dalam menggunakan alat sanitarian kit Semoga bermanfaat Jangan lupa like, ... Watch Now
Watch Now
- REAL Graham Test

REAL Graham Test for detection of Enterobius vermicularis Protocol for sampling. More information: http://reallaboratory.com/product/graham-test-safe-clean/ Watch Now
Watch Now
- Uji CSL mhs FKK UMJ pengambilan,pemeriksaan sedian hapus sekret uretra

 Watch Now
Watch Now
- Pemeriksaan Feses Metode Pengapungan Analis Kesehatan Poltekkes Tanjung Karang

Pemeriksaan parasit dengan sampel feses pada manusia atau hospes dapat dilakukan dengan pemeriksaan kualitatif dan kuantitatif. Pemeriksaan feses ... Watch Now
Watch Now
- Pengenalan alat praktikum mikrobiologi dan parasitologi dasar farmasi pelamonia

Pengenalan alat-alat yang digunakan dalam praktikum mikrobiologi dan parasitologi dasar Farmasi A17 Sekolah tinggi ilmu kesehatan pelamonia makassar. Watch Now
Watch Now
- Parasitologi

 Watch Now
Watch Now
- Isolasi mikroorganisme // mikrobiologi & parasitologi// Putra Indonesia Malang

Ini tahap 1... Pengambilan sampel untuk di inkubasi, yang selanjutnya akan masuk tahap 2 yaitu isolasi...... Nunggu bberapa hari dulu yah... Watch Now
Watch Now
- Video Skill Lab Semester 4 | Swab Uretra FK UNEJ 2018

Kali ini pendpro membuat tutorial tentang swab uretra loh, silahkan di simak yey! Swab Uretra merupakan skill yang harus dikuasai mahasiswa semester 4. Watch Now
Watch Now
- Pengambilan Sampel Rectal Swab di Instalasi Gizi RSUD Kab Buleleng

 Watch Now
Watch Now
Saturday, September 21, 2019
Metode Swab Adalah
Subscribe to:
Post Comments (Atom)
No comments:
Post a Comment